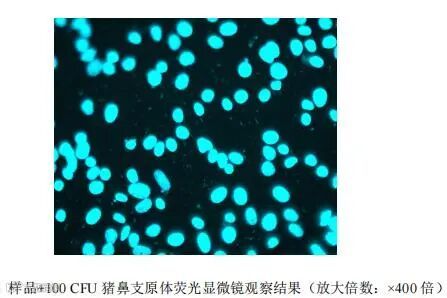
图片

本文核心要点速览:
|
1 |
法规里程碑:2026年生效的《欧洲药典》2.6.7修订案正式将NAT法提升为与培养法、指示细胞培养法并行的三大核心方法之一,明确其替代合规路径。 |
|
2 |
技术要求:新版EP强调细胞与上清同检、强制抑制物测试、引入WHO标准品及GC/CFU<10的参考品标准,使NAT验证更具量化依据。 |
|
3 |
验证核心:可比性研究是通行证,NAT法灵敏度需达≤10 CFU/mL(替代培养法)或≤100 CFU/mL(替代指示细胞培养法),并完成专属性、耐用性及抑制物测试。 |
|
4 |
|
在CAR-T细胞产品的生产质控中,放行质量检测周期与产品生命周期错配始终是质量控制的焦点难题。产品制备已经完成,患者已准备就绪,而支原体检查传统法(培养法)长达28天的检测周期,往往远超细胞治疗产品仅数天的有效期。这一矛盾,在先进治疗药品(ATMPs)领域尤为突出——每延迟一天放行,患者生存窗口就缩小一分。
传统培养法不仅周期长,还存在"活的非可培养状态"(VBNC)支原体漏检风险;指示细胞培养法虽缩短至7-10天,但操作繁琐,时间上仍然无法满足快速放行需求。核酸扩增技术(NAT)的出现,为这一问题提供了技术层面的解决方案。基于支原体特异性DNA序列的扩增与检测,NAT方法可将检测周期缩短至3-5小时,实现真正意义上的“快检放行”。
2026监管新规:
NAT法地位确立与技术框架升级
2026年对于支原体NAT检测而言是关键的历史性节点,欧洲药品质量管理局(EDQM)于2025年5月13日发布官方新闻,确认了EP 2.6.7(12.2版)的修订内容 。根据即将生效的《欧洲药典》(12.2版)2.6.7“支原体(MYCOPLASMAS)”修订案(生效日期为2026年4月1日),NAT法再次明确为与培养法、指示细胞培养法并行的三大核心方法之一。这意味着,在经过充分验证的前提下,NAT法已具备替代传统药典方法的合规基础。

新版EP关于NAT法的主要技术更新包括:
检测范围扩展与分类细化:明确涵盖柔膜体纲(Mollicutes),包括支原体属、脲原体属、无胆甾原体属及螺原体属等,检测范围扩大,分类更细化。
取样策略的科学性提升:强调由于支原体可能附着或存在于细胞内,检测时应同时取样细胞和上清液。
抑制物测试的强制性要求:与培养法一致,指示细胞培养法和核酸法均新增抑制物测试,并提出了具体方案和测试内容,旨在排除产品基质对PCR反应的干扰。
验证标准量化:引入WHO支原体DNA国际标准品作为校准工具,并明确规定GC/CFU比率<10的参考品接受标准,使NAT结果更具可比性。(更多维度解读,请点击:为什么支原体菌株质量决定了核酸扩增法中LOD是否“真实可信”?)
点击链接了解更多→“EP 2026新版支原体检测要求,从正确取样开始 ——上清&细胞缺一不可”
方法学验证:
NAT快检的合规通行证
对于细胞治疗企业而言,采用NAT方法的核心顾虑在于监管合规性。目前,《欧洲药典》(EP)、《日本药典》(JP)以及《美国药典》(USP)均已收录NAT方法作为支原体检测方法;2025版《中国药典》虽尚未正式收录,但也明确指出“也可采用经国家药品检定机构认可的其他方法”。各国药监机构对支原体检测方法的认可逻辑高度一致:新方法可以接受,但必须证明其不劣于现有方法。
根据2022年国家药监局药审中心发布的《细胞治疗产品药学研究与评价技术指导原则》(试行),在样品量有限或需要快速放行的特殊情况下,如药典方法无法满足,可考虑开发新型检测方法,但必须经过充分验证。NAT法的验证路径主要围绕可比性研究展开,即证明新方法不劣于于或优于传统方法:

完整的验证体系还应涵盖专属性、耐用性、抑制物测试(针对特定产品)以及21 CFR Part 11合规的电子记录管理。
湖州申科支原体NAT检测服务体系
基于上述法规框架与技术逻辑,湖州申科构建了符合中美欧三方药典要求的完整支原体NAT检测与验证服务体系,致力于解决CGT企业“方法建立难、验证周期长、监管沟通成本高”的特点:
平台资质:CNAS认可;BSL-2加强型实验室;
试剂盒性能:MycoSHENTEK®支原体检测试剂盒经三方室间验证,灵敏度可达10 CFU/mL,覆盖支原体及相关菌属约200种;已获得FDA DMF备案(备案号:MF29624);
验证菌株:所有验证菌株溯源至知名保藏机构,获正式授权,符合EP对菌株参考品GC/CFU比率的要求;
法规解读与监管沟通支持:深度解读中美欧药典差异,协助企业制定最优验证策略;配备具有药检/药监部门沟通经验的技术团队,协助撰写方法学验证及可比性研究方案并完成服务委托,支持现场核查;
项目覆盖:支原体NAT检测与可比性研究服务解决方案已广泛应用于国内成功IND的CGT项目,并助力BLA关键性研究与产品的上市后变更。
实战案例:
已上市CAR-T产品的方法变更
项目背景:
某已上市CAR-T产品,采用MycoSHENTEK®支原体qPCR检测试剂盒实现快速放行。
技术挑战:
• 产品为自体细胞制剂,批次间差异大,基质效应复杂。
• 需证明NAT法对培养法(28天)和指示细胞培养法(7天)的双重替代等效性。
• 验证方案符合法规及监管要求,需通过药检部门的测试复核。
验证路径:
按照EP 2.6.7及国内指导原则,开展方法学验证及可比性研究。同步使用NAT法与传统法对相同样品及菌株进行检测,重点考察方法检测限、专属性及耐用性。
申报结果:
验证方案及报告获监管认可,顺利完成复核检,实现已上市产品由培养法向NAT法的的合规变更。

图1:指示细胞培养法比对
图2:培养法比对(样品+口腔支原体/肺炎支原体培养结果)
从28天到3小时,改变的不仅是时间尺度,更是质控逻辑的迭代。在ATMPs时代,充分验证的NAT方法,正在成为连接产品安全与临床可及性的合规桥梁。
随着EP 2.6.7 (12.2)、USP <77>、ChP 2025等法规的陆续实施,支原体NAT检测已从"替代方法"升级为"核心方法"。对于CGT企业而言,选择具备深度法规理解能力、特定产品验证经验、本土化响应速度的服务商,将是实现合规快检放行的关键。
湖州申科将持续跟踪全球监管动态,以MycoSHENTEK®技术平台为基础,为创新药企提供符合国际最高标准的支原体检测解决方案,助力先进治疗药品的安全、快速上市。

想要了解更多或申请样机试用,请联系我们




